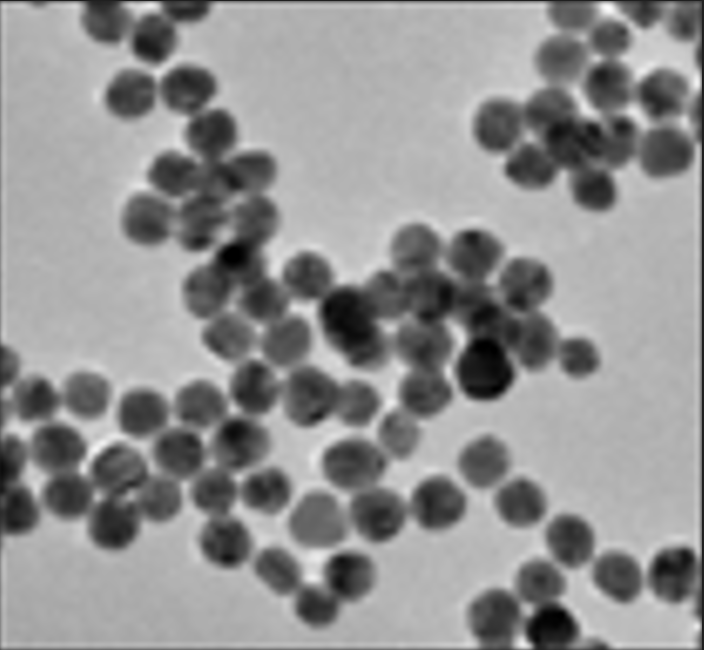
水溶性金纳米颗粒

南京卓升生物技术 | 纳米材料合成与生物医学应用专家 - 科研定制诊疗制剂研发
服务优势
-




前沿技术引领创新
运用先进技术,如纳米技术用于靶向递送,优化材料表面改性,为客户提供领先行业的解决方案,助力科研与产业突破。
-




多元产品满足需求
涵盖磁性、金、银、硅纳米材料,及各类微球产品,丰富的产品种类,能满足不同客户在科研、生产等多场景下的多样化需求。
-




全面服务贴心支持
除材料供应,还提供蛋白偶联、靶向递送、检测等技术服务,一站式服务体系,全程助力客户项目推进,省心又省力。
-




严格质控保障品质
从材料生产到技术服务,遵循严格标准,对磁性微纳米材料等产品及各项服务精细把控,确保交付高品质成果。
公司简介

南京卓升生物技术有限公司专注纳米材料合成与生物医学应用,提供磁性/稀土/自组装纳米材料及全链条研发服务。拥有博士硕士研发团队,覆盖材料制备、表面修饰、细胞/动物实验到体外诊断试剂、分子影像探针开发,助力科研高分文章及产业化发展。
生态伙伴
留下您的联系方式,方便与我们取得联系
坚持精益求精,提供优质的产品与服务